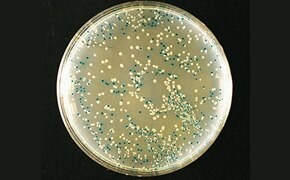

Molecular Biology & Genomics Learning Hub
Introduction
From routine cloning, rapid nucleic acid purification, reliable PCR amplification, and novel CRISPR gene editing tools, get the time and resource-saving benefits of our molecular tools that are ready when you are. Our highly proven molecular reagents provide a range of “grab-and-go” tools so that you can select from a variety of gold-standard offerings and solutions that scale from bench-top R&D to production-level needs. Explore technical resources for cloning, expression, nucleic acid purification, PCR, gene editing, and NGS applications.
Webinars
Sign In To Continue
To continue reading please sign in or create an account.
Don't Have An Account?